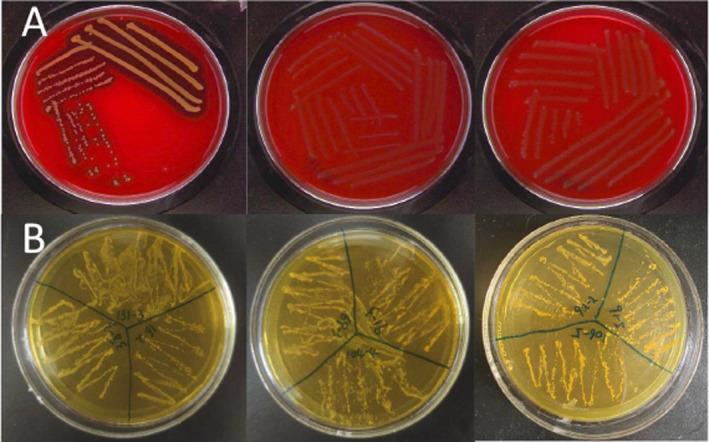
https://cdn.ncbi.nlm.nih.gov/pmc/blobs/98ef/11717038/dd174909f750/FSN3-13-e4592-g010.jpg
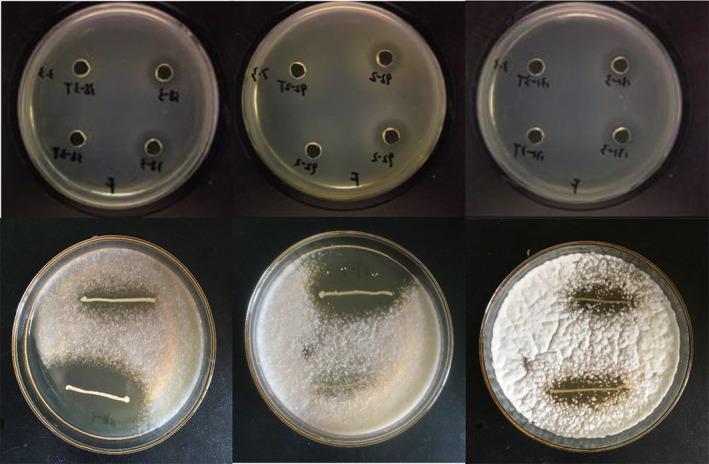
https://cdn.ncbi.nlm.nih.gov/pmc/blobs/98ef/11717038/a86ce6524fa0/FSN3-13-e4592-g007.jpg
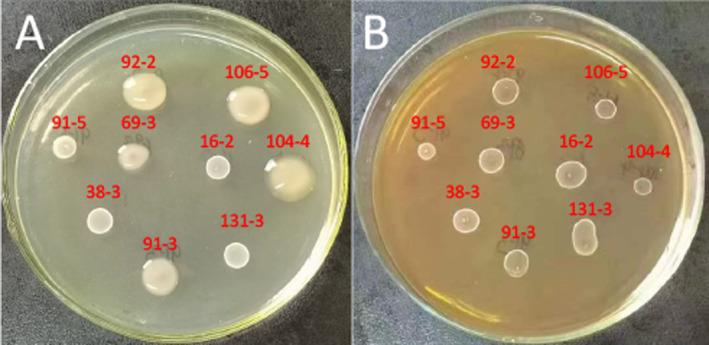
https://cdn.ncbi.nlm.nih.gov/pmc/blobs/98ef/11717038/3543422c074f/FSN3-13-e4592-g002.jpg

中国陕西西安发酵蔬菜中 属菌种的安全性及益生菌特性评估。 (你提供的原文中“ spp.”部分不太完整,推测可能是某种具体的菌属名称,但仅按现有内容翻译如上。)
Evaluation of Safety and Probiotic Properties of spp. in Fermented Vegetables From Xi'an, Shaanxi, China.
作者信息
Liu Chen, An Chao, Zhang Jingjing, Liu Yao, Zhang Qiwen, Ding Hao, Ma Saijian, Xue Wenjiao
机构信息
Shaanxi Institute of Microbiology Xi'an China.
Shaanxi Key Laboratory of Qinling Ecological Security Shaanxi Academy of Sciences Xi'an China.
出版信息
Food Sci Nutr. 2024 Dec 2;13(1):e4592. doi: 10.1002/fsn3.4592. eCollection 2025 Jan.
The genus , commonly found in fermented foods, is a significant group of lactic acid bacteria (LAB) with potential probiotic properties. Several strains have been proposed as probiotics due to their biotechnological capabilities. However, a few strains may exhibit opportunistic pathogenic behavior, which restricts the widespread use of all strains in food applications. This study sought to expand our understanding of the biotechnological capabilities of spp. by examining the safety and functional characteristics of strains isolated from spontaneous fermentation. In this investigation, nine strains were evaluated for their safety and probiotic potential. The safety assessment revealed that the antibiotic resistance profiles of strains 16-2, 38-3, 69-3, 91-3, 91-5, 104-4, and 106-5 were comparable or superior to the reference strain LGG. Hemolytic activity and ammonia production were also evaluated, but no positive results were observed. Further probiotic experiments demonstrated that strain 91-5 exhibited superior performance in several areas, including survival rates in simulated gastrointestinal fluids, cell surface properties (hydrophobicity and adhesion to Caco-2 cells), ABTS+ scavenging ability, antimicrobial activity, and cholesterol assimilation in vitro. Additionally, strain 104-4 produced an exopolysaccharide (EPS) yield of 35.11 g/L after 48 h of culture in MRS-sucrose (60 g/L) medium, surpassing most previously reported values. These findings suggest that strains 91-5 and 104-4 show promise as potential probiotic candidates for the development of new functional food supplements. Furthermore, this research expands the theoretical basis for considering strains as novel probiotics.
该属常见于发酵食品中,是一类具有潜在益生菌特性的重要乳酸菌(LAB)。由于其生物技术能力,一些菌株已被提议作为益生菌。然而,少数菌株可能表现出机会致病行为,这限制了所有菌株在食品应用中的广泛使用。本研究旨在通过检查从自发发酵中分离的菌株的安全性和功能特性,扩大我们对该属生物技术能力的理解。在这项调查中,对9株该属菌株的安全性和益生菌潜力进行了评估。安全性评估显示,菌株16 - 2、38 - 3、69 - 3、91 - 3、91 - 5、104 - 4和106 - 5的抗生素抗性谱与参考菌株LGG相当或更优。还评估了溶血活性和氨产生,但未观察到阳性结果。进一步的益生菌实验表明,菌株91 - 5在几个方面表现优异,包括在模拟胃肠液中的存活率、细胞表面特性(疏水性和对Caco - 2细胞的粘附性)、ABTS +清除能力、抗菌活性以及体外胆固醇同化能力。此外,菌株104 - 4在MRS - 蔗糖(60 g/L)培养基中培养48小时后,胞外多糖(EPS)产量为35.11 g/L,超过了大多数先前报道的值。这些发现表明,菌株91 - 5和104 - 4有望成为开发新型功能性食品补充剂的潜在益生菌候选菌株。此外,本研究扩展了将该属菌株视为新型益生菌的理论基础。